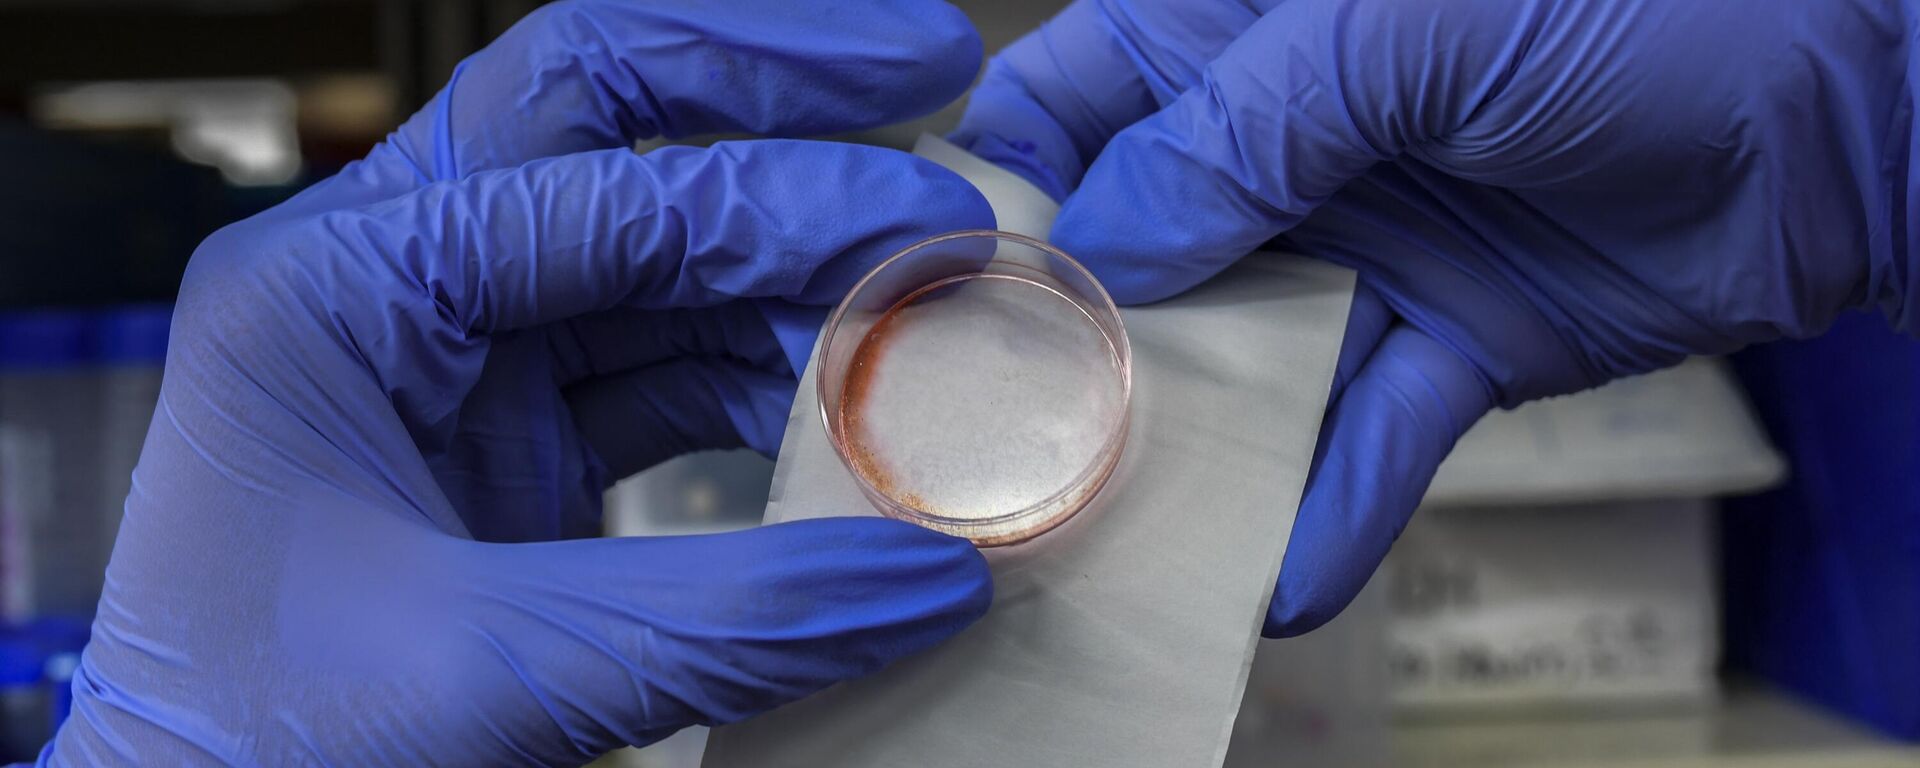
الخلايا الجذعية - سبوتنيك عربي, 1920, 07.09.2023

https://sarabic.ae/20260107/دراسة-ملايين-الخلايا-من-الأم-تعيش-داخل-أبنائها-مدى-الحياة-1108981468.html
دراسة: ملايين الخلايا من الأم تعيش داخل أبنائها مدى الحياة
دراسة: ملايين الخلايا من الأم تعيش داخل أبنائها مدى الحياة
سبوتنيك عربي
كشفت دراسة علمية حديثة، نشرت في مجلة "Immunity"، أن كل إنسان يحمل في جسمه ملايين الخلايا المنتمية جينياً إلى أمه، وأن هذه الخلايا لا تُعامل كـ"دخيلة" كما تقتضي... 07.01.2026, سبوتنيك عربي
2026-01-07T08:45+0000
2026-01-07T08:45+0000
2026-01-07T08:45+0000
مجتمع
منوعات
الولايات المتحدة الأمريكية
https://cdn.img.sarabic.ae/img/07e7/07/13/1079216060_0:335:2924:1980_1920x0_80_0_0_3e32d1f40ba8ecbe9879e0ebdd120cd4.jpg
وأظهرت الأبحاث أن نحو خلية واحدة من كل مليون خلية في جسم الإنسان مصدرها الأم، وهي ظاهرة معروفة علمياً باسم "التكاثر الخلوي الدقيق" (Microchimerism)، تم رصدها منذ أكثر من خمسين عاماً. وتحدث العملية في الاتجاهين، إذ تحتفظ الأم أيضاً بخلايا من أجنّتها، بحسب ما ذكر موقع "ساينس أليرت".لكن اللغز الذي حيّر علماء المناعة طويلاً هو كيف يتجنب الجهاز المناعي مهاجمة هذه الخلايا "الغريبة"، رغم مهمته الأساسية في التمييز بين "الذات" و"غير الذات".وأجرى الباحثون تجارب على فئران معملية باستخدام خلايا مناعية أمومية معدلة وراثياً يمكن تتبعها أو تعطيلها بدقة.وتبين أن مجموعة صغيرة جداً من هذه الخلايا – تشبه خلايا نخاع العظم والخلايا المتغصنة – تلعب دوراً حاسماً في تعزيز نشاط "الخلايا التائية التنظيمية"، المسؤولة عن تهدئة الجهاز المناعي ومنعه من مهاجمة الأنسجة السليمة.وعند إزالة هذه الخلايا الأمومية تحديداً، اختفت الخلايا التائية التنظيمية، وانهار التسامح المناعي تجاه خلايا الأم، مما أدى إلى ما وصفه الباحثون بـ"فوضى مناعية".يرى الباحثون أن هذا الاكتشاف يفتح أبواباً واسعة لفهم أمراض المناعة الذاتية، والسرطان، واضطرابات الجهاز العصبي، التي يُشتبه في دور ظاهرة التكاثر الخلوي الدقيق فيها.كما أكدوا أن الأدوات الجديدة لتتبع هذه الخلايا ستساعد في المستقبل على تحديد ما إذا كانت سببًا مباشراً لبعض الأمراض، أم أنها تتكاثر كرد فعل تعافٍ طبيعي في الأنسجة المصابة.تؤكد الدراسة أن الرابط البيولوجي بين الأم وأبنائها لا ينتهي عند الولادة، بل يستمر على المستوى الخلوي، مشكلاً علاقة خفية ومعقدة تمتد مدى العمر.
https://sarabic.ae/20260104/دراسة-الخلايا-البشرية-قد-تولد-الكهرباء-ذاتيا-1108896198.html
https://sarabic.ae/20230907/باحثون-ينشئون-نماذج-أجنة-بشرية-من-الخلايا-الجذعية-1080780434.html
https://sarabic.ae/20230719/علماء-يكتشفون-كوكتيلا-يعكس-شيخوخة-الخلايا-البشرية-1079215523.html
الولايات المتحدة الأمريكية
سبوتنيك عربي
feedback.arabic@sputniknews.com
+74956456601
MIA „Rossiya Segodnya“
2026
سبوتنيك عربي
feedback.arabic@sputniknews.com
+74956456601
MIA „Rossiya Segodnya“
الأخبار
ar_EG
سبوتنيك عربي
feedback.arabic@sputniknews.com
+74956456601
MIA „Rossiya Segodnya“
سبوتنيك عربي
feedback.arabic@sputniknews.com
+74956456601
MIA „Rossiya Segodnya“
منوعات, الولايات المتحدة الأمريكية
منوعات, الولايات المتحدة الأمريكية
دراسة: ملايين الخلايا من الأم تعيش داخل أبنائها مدى الحياة
كشفت دراسة علمية حديثة، نشرت في مجلة "Immunity"، أن كل إنسان يحمل في جسمه ملايين الخلايا المنتمية جينياً إلى أمه، وأن هذه الخلايا لا تُعامل كـ"دخيلة" كما تقتضي قواعد الجهاز المناعي، بل تتعايش سلمياً مدى الحياة بفضل آلية تدريب مناعي دقيقة تبدأ في الرحم.
وأظهرت الأبحاث أن نحو خلية واحدة من كل مليون خلية في جسم الإنسان مصدرها الأم، وهي ظاهرة معروفة علمياً باسم "التكاثر الخلوي الدقيق" (Microchimerism)، تم رصدها منذ أكثر من خمسين عاماً. وتحدث العملية في الاتجاهين، إذ تحتفظ الأم أيضاً بخلايا من أجنّتها، بحسب ما ذكر
موقع "ساينس أليرت".
لكن اللغز الذي حيّر علماء المناعة طويلاً هو كيف يتجنب الجهاز المناعي مهاجمة هذه الخلايا "الغريبة"، رغم مهمته الأساسية في التمييز بين "الذات" و"غير الذات".
قاد فريق بحثي من مركز مستشفى سينسيناتي للأطفال في الولايات المتحدة الدراسة، وكشف أن عددًا محدوداً من الخلايا المناعية الأمومية يعبر المشيمة أثناء الحمل، ويبقى في جسم المولود لفترات طويلة بعد الولادة.
وأجرى الباحثون تجارب على فئران معملية باستخدام
خلايا مناعية أمومية معدلة وراثياً يمكن تتبعها أو تعطيلها بدقة.
وتبين أن مجموعة صغيرة جداً من هذه الخلايا – تشبه خلايا نخاع العظم والخلايا المتغصنة – تلعب دوراً حاسماً في تعزيز نشاط "الخلايا التائية التنظيمية"، المسؤولة عن تهدئة الجهاز المناعي ومنعه من مهاجمة الأنسجة السليمة.
وعند إزالة هذه الخلايا الأمومية تحديداً، اختفت الخلايا التائية التنظيمية، وانهار التسامح المناعي تجاه خلايا الأم، مما أدى إلى ما وصفه الباحثون بـ"فوضى مناعية".
وخلصت الدراسة إلى أن تقبل الجهاز المناعي لخلايا الأم ليس حدثاً مؤقتاً يقتصر على فترة الحمل، بل عملية نشطة ومستمرة تتطلب وجود هذه الخلايا "الحارسة" طوال الحياة.
يرى الباحثون أن هذا الاكتشاف يفتح أبواباً واسعة لفهم أمراض المناعة الذاتية،
والسرطان، واضطرابات الجهاز العصبي، التي يُشتبه في دور ظاهرة التكاثر الخلوي الدقيق فيها.
كما أكدوا أن الأدوات الجديدة لتتبع هذه الخلايا ستساعد في المستقبل على تحديد ما إذا كانت سببًا مباشراً لبعض الأمراض، أم أنها تتكاثر كرد فعل تعافٍ طبيعي في الأنسجة المصابة.
تؤكد الدراسة أن الرابط البيولوجي بين الأم وأبنائها لا ينتهي عند الولادة، بل يستمر على المستوى الخلوي، مشكلاً علاقة خفية ومعقدة تمتد مدى العمر.